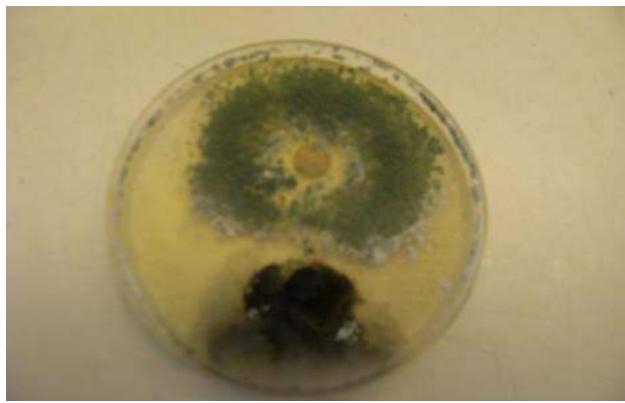
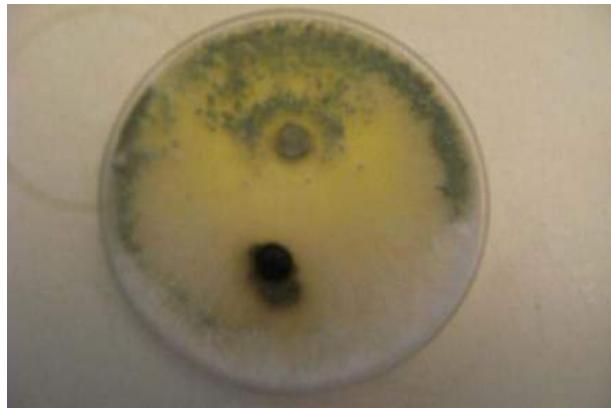
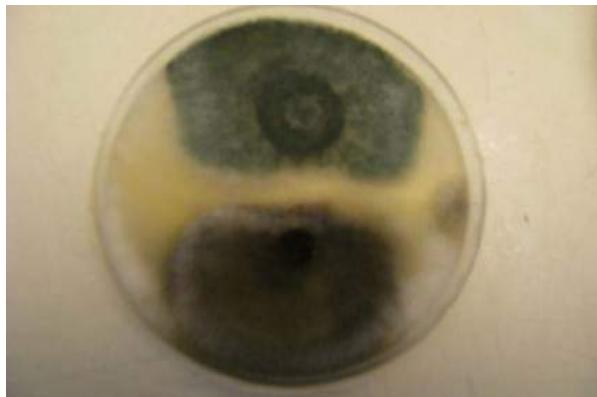
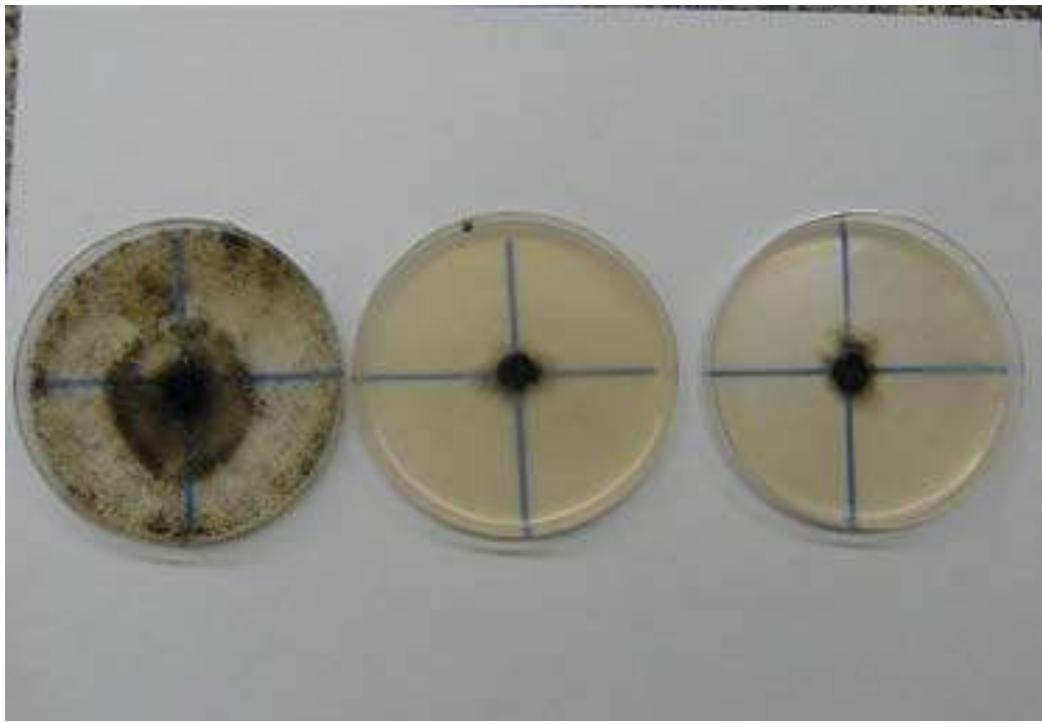

In vitro Testing of the Trichoderma Species as Bio-control Agents of (Neofusicoccum. mangiferae .Crous) Pathogen of Branch Disease in Shade and Fruit Trees
This study carried out in 2013 to test the fungicidal potentiality of three Trichoderma species under laboratory condition. The laboratory experiments were conducted at the laboratory of plant quarantine-Administration of Plant Protection Ministry of Agriculture. Any Trichoderma specie was considered as treatment in addition to one synthetic fungicide (Amstar-Top) for comparison, each treatment replicated 6 times and arranged in CRD. The result revealed that: Amistar-Top at concentration of 200 ppm, had given significant inhibition compared with the three species of Trichoderma with different isolates of the pathogen. However, there was no significant difference between inhibition percentages from Amistar-Top in some treatments. More over T. harzianum with N. mangiferae isolated from Mangifera indica and T. viride with the fungal isolate from F. benjamina were more effective than Amistar-Top.
## I. INTRODUCTION
One of the strategies used to control pathogens is mycoparasitism whereby a species or strain of fungus directly attacks and feeds on other fungi (Harman, 2000). The antagonistic ability of Trichoderma species was discovered 70 years ago. Trichoedrma spp. are now the most common fungal biological control agents throughout the world. The primary mechanism of antagonism in Trichoderma is mycoparaasitism (Chet, 1987).
Over the past several decades, various attempts to control plant diseases have been made for eradication or prevention through the development of systemic fungicides. Continued and repeated application of fungicides has disturbed the biological control by natural enemies and let to out-break in disease and development of resistance to various types of fungicides toxicity to non-target organisms and environmental problems (Hayes and Law, 1991). In addition, use of fungicides is uneconomic due to longevity of trees that necessitates repeated application over a long period of time. Triazoles antifungal such as tebuconazole are now widely used for treatment of fungal infections due to their broad spectra activity and improved safety profile compared to other fungicides (Kamai et al., 2002).
Due to the importance of bio-agents to control plant diseases, this work is considered a contribution in this aspect especially, to test inhibition activity of three Trichoderma species to $N$. mangiferae.
## II. MATERIALS AND METHODS
### a) Effect of Trichoderma Species on the Growth of N. Mangiferae
Three species of the genus Trichoderma were obtained from the laboratory of plant quarantine-Administration of Plant Protection, Ministry of Agriculture. Active pure culture from each species was prepared by transferring samples from each species into PDA plates and incubated at $28^{\circ}\mathrm{C}$ for seven days (until the Petri dishes completely covered). Five mm discs of PDA from seven days old culture of each isolate of $N$. mangiferae and the same size disc from seven days old cultures of Trichoderma species were placed 3 cm apart from each other and 3 cm from the edge of the plate. The antagonistic potentiality of the three Trichoderma species against $N$. mangiferae isolates was measured as inhibition% considering the radial growth in the opposite directions from the centre of the inoculums discs as control (R) and the growth towards the disc of pathogen as treatment $(R_{1})$. The inhibition percent was calculated according to the following formula;
$$
I\% = R-R_{1}/R
$$
$$
1 \% = \text{Inhibition percentage}
$$
Whereas $R =$ the growth length from the centre of the inoculums disc towards the edge of the plate $R_{1} =$ the growth towards Trichoderma disc
### b) Effect of Amistar-Top on the Radial Growth of N. Mangiferae
Five mm discs of PDA from seven days old culture of each isolate of $N$. mangiferae and placed in the center of PDA media amended with different concentrations of the fungicide (Amstar-Top), clean discs were placed for control treatment. The fungicidal potentiality of Amstar-Top was measured as inhibition% considering the radial growth from the center of the Petri-dish. The inhibition percent was calculated according to the following formula;
$$
1\% = \frac{D-D_1}{D}
$$
$$
1\% = \text{Inhibition percentage}
$$
Whereas $D =$ growth diameter in control, $D1 =$ growth diameter in the treatment
## III. RESULTS
a) Effect of Trichoderma Species on the Radial Growth of Four Isolates of N. Mangiferae
The biological interaction between N. mangiferae isolates and Trichoderma spp. resulted into reduction of the radial growth of the N. mangiferae In vitro. The inhibition percent ranged between $49.8\%$ and $82.14\%$ (Fig-1). Trichoderma viride was the most effective against N. mangiferae isolated from C. lemon, it has resulted in $82.14\%$ inhibition percent. The least inhibition percent was of N. mangiferae was that of T. koningei with N. mangiferae isolated from F. nitida. However the statistical analysis showed no significant differences between the means of inhibition percent regarding different Trichoderma spp. (Table 1).
Table 1: Inhibition Percentages of Radial Growth of Four N. Mangiferae Isolates Treated with Three Trichoderma Species
<table><tr><td rowspan="4">Treatments (Trichoderma species)</td><td colspan="4">Isolates of N. Mangiferae</td></tr><tr><td colspan="4">Host plants</td></tr><tr><td colspan="4">Inhibition%</td></tr><tr><td>Citrus lemon</td><td>F. benjamina</td><td>F. nitida</td><td>M. Indica</td></tr><tr><td>T. harzianum</td><td>78.44a</td><td>49.80a</td><td>53.02a</td><td>66.90 a</td></tr><tr><td>T. viride</td><td>82.14a</td><td>64.30a</td><td>68.54a</td><td>78.82 a</td></tr><tr><td>T. koningei</td><td>78.76a</td><td>54.96a</td><td>50.86a</td><td>72.78a</td></tr><tr><td>LSD</td><td>17.63</td><td>18.47</td><td>35.77</td><td>18.47</td></tr></table>
Mean with the same letter(s) in the column are not significantly different at $\mathrm{P} < 0.05$.

Fig.-1: Effect of Trichoderma Spp. on the Radial Growth of N. Mangiferae
### b) Effect of Different Concentration of Amistar-Top on the Radial Growth of N. Mangiferae Isolates
The systemic fungicide Amistar-top was very effective in reduction of radial growth of $N$. mangiferae isolates. Three concentrations of the fungicide have been tested In vitro: 100, 200 and 500 ppm. The results showed that there was no significant difference between the two concentrations of 200ppm and 500ppm, but they differed significantly from the concentration of 100ppm. This result means that the concentrations 200ppm and 500ppm have the same efficacy (Table-2) and (Fig-2).
Table-2: Effect of Amistar- Top on the Radial Growth of Four Isolates of N. Mangiferae
<table><tr><td rowspan="4">Concentrations</td><td colspan="4">Isolates of N. mangiferae</td></tr><tr><td colspan="4">Host plants</td></tr><tr><td>C. lemon</td><td>F. benjamina</td><td>F. nitida</td><td>M. indica</td></tr><tr><td colspan="4">Inhibition%</td></tr><tr><td>100ppm</td><td>55.98b</td><td>52.96 b</td><td>52.04b</td><td>51.06b</td></tr><tr><td>200ppm</td><td>88.08a</td><td>85.16a</td><td>82.72a</td><td>85.00a</td></tr><tr><td>500ppm</td><td>90.44a</td><td>89.64a</td><td>90.32a</td><td>90.75a</td></tr><tr><td>LSD</td><td>8.077</td><td>19.92</td><td>17.30</td><td>12.43</td></tr></table>
Mean with the same letter(s) in the column are not significantly different at $P < 0.05$.
Fig.-2: Effect of Amistar Top on the Radial Growth of N. Mangiferae
c) Effect of Three Trichoderma Species on the Growth of N. Mangiferae Isolates Compared with Amistar-Top
The bio-agents tested were compared with the fungicide Amistar-Top tested in the laboratory showed that Trichodema spp. have approximately similar effect as Amistar-Top on the pathogen isolates radial growth and (Fig-3). Amistar-top with $N$. mangiferae isolated from $M$. indica was significantly better than $T$. harzianum. However, there was no significant differences between Amistar-Top effect and $T$. viride with $N$. mangiferae isolated from Citrus lemon, Ficus nitida and mangiferae indica. On the other hand Amistar-top showed its significant superior to T. viride with N. mangiferae isolated from F. benjamina.
 Fig.- 3: Comparison of Inhibition Effect (%) of Three Trichoderma Spp. and Amistar on Four Isolates of N. Mangiferae
## IV. DISCUSSION
Trichoerman spp. plays a major role as biocontrol agents, owing to their capability of improving crop yield by multiple roles, such as bio-pesticide, bioherbicide and plant growth promotion (Mausam, 2007). Currently the roles of BCAs are a well-established fact and become increasingly crucial, and in several cases complementary or even replacing the synthetic chemical components where antagonistic fungi play an important part (Templeten, and Heiny, 1989). Bio-interaction between Trichoderma spp. and plant pathogenic fungi tested in the laboratory showed that Trichoderma species were differently effective in inhibiting the different isolates of the pathogen (N. mangiferae). T. viride gave the highest inhibitory action on N. mangiferae isolated from symptomatic lime tree with $80\%$ inhibition. In counterpart T. harzianum have the least inhibition with N. mangiferae isolated from F. benjamina with $49.8\%$ inhibition. This inhibition of the pathogen can be attributed to the different biological interactions between Trichoderma spp. and the pathogen. The systemic fungicide Amstar-Top was used as reference revealed that it is highly effective in reducing the radial growth of different isolates of the pathogen, exactly $88.08\%$ inhibition. This is due to the fact that in case of synthetic chemical fungicides the formulations applied are very accurately calculated according to the recommendations of the company. On the other hand in case of bio-control agents it is difficult to setup formulations for application as the activity of the control agent is subjected to biological factors and environmental conditions. This fact may give the farmer evident to rely on chemicals more than bio-agents application.
Generating HTML Viewer...
References
6 Cites in Article
I Chet (1987). Trichderma application, mode of action, and potential as a biological control agent of soilborne plant fungi.
G Harman (2000). Myths and Dogmas of Biocontrol Changes in Perceptions Derived from Research on <i>Trichoderma harzinum</i> T-22.
W Hayes,Jr,E Laws (1991). Handbook of pesticide toxicology.
Y; Kamai,T; Harasaki,T; Fukuoka,S; Ohya,K Uchida,H ; Yamaguchi,S Kuwahara (2002). In vitro and in vivo activities of CS-758 (R-120758), a new triazole antifungal agent.
V Mausam,K Satinder,R Brar,R Tyagi,J Surampalli (2007). Antagonistic fungi Trichoderma spp. Pansophy of Biological Control.
G Templeten,D Heiny (1989). Improvement of fungi to enhance mycoerbicide potential.
No ethics committee approval was required for this article type.
Data Availability
Not applicable for this article.
How to Cite This Article
Fatin Abdalla Osman. 2026. \u201cIn vitro Testing of the Trichoderma Species as Bio-control Agents of (Neofusicoccum. mangiferae .Crous) Pathogen of Branch Disease in Shade and Fruit Trees\u201d. Global Journal of Science Frontier Research - D: Agriculture & Veterinary GJSFR-D Volume 22 (GJSFR Volume 22 Issue D3).
Explore published articles in an immersive Augmented Reality environment. Our platform converts research papers into interactive 3D books, allowing readers to view and interact with content using AR and VR compatible devices.
Your published article is automatically converted into a realistic 3D book. Flip through pages and read research papers in a more engaging and interactive format.
Our website is actively being updated, and changes may occur frequently. Please clear your browser cache if needed. For feedback or error reporting, please email [email protected]
Thank you for connecting with us. We will respond to you shortly.
Lorem ipsum dolor sit amet, consectetur adipiscing elit. Ut elit tellus, luctus nec ullamcorper mattis, pulvinar dapibus leo.
In vitro Testing of the Trichoderma Species as Bio-control Agents of (Neofusicoccum. mangiferae .Crous) Pathogen of Branch Disease in Shade and Fruit Trees